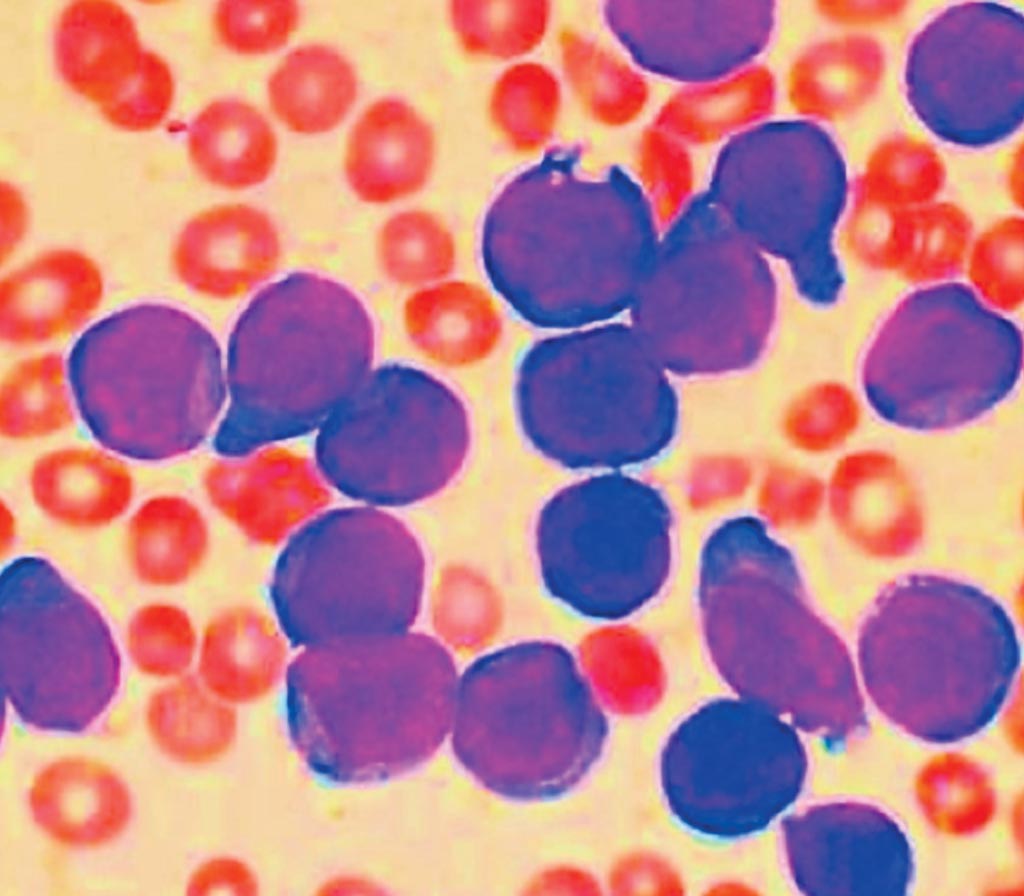
Окрашенный мазок пунктата костного мозга пациента с острым лимфобластным лейкозом из клеток-предшественников В-лимфоцитов (фото любезно предоставлено VashiDonsk).

Недостающие фрагменты ДНК могут предсказать рецидив лейкоза
By LabMedica International staff writers
Posted on 17 Jan 2018
Разработана новая система балльной оценки риска для детей, больных лейкозом, на основе недостающих фрагментов ДНК, или микроделеций. Шкала рисков позволит врачам лучше прогнозировать вероятность рецидива в подгруппе детей, которые в настоящее время скрыты в группе пониженного риска.Posted on 17 Jan 2018
Новый вид шкалы рисков, который основывается на исследовании костного мозга, анализе минимального остаточного заболевания, или MRD-анализе, который дает врачам заблаговременное предупреждение о том, что лечение может не дать результата. MRD-анализ настолько чувствительный, что позволяет обнаружить единственную опухолевую клетку среди миллиона клеток костного мозга, выжившую в ходе противоопухолевой терапии. Этот анализ был огромным благом для некоторых детей с лейкемией в рамках клинических исследований, поскольку он позволил предупредить врачей об очень высоком риске возникновения рецидива. В связи с этим они проводили очень интенсивное лечение с применением химиотерапии и трансплантации костного мозга, и выживаемость в этой подгруппе увеличилась вдвое, однако одного лишь MRD-анализа недостаточно.
Окрашенный мазок пунктата костного мозга пациента с острым лимфобластным лейкозом из клеток-предшественников В-лимфоцитов (фото любезно предоставлено VashiDonsk).
Группа ученых, сотрудничающих с Австралийским институтом детской онкологии (Сидней, Австралия), исследовала 475 пациентов из шести различных детских больниц в Австралии и Новой Зеландии, которые были включены в клиническое исследование. Среди пациентов были дети с острым лимфобластным лейкозом из клеток-предшественников В-лимфоцитов невысокой степени риска, одним из подтипов острого лимфобластного лейкоза – наиболее распространенной формы рака у детей, выживаемость при которой обычно составляет около 90%. У большинства детей, больных острым лимфобластным лейкозом, был острый лимфобластный лейкоз из клеток-предшественников В-лимфоцитов.
Розмари Саттон (Rosemary Sutton), доктор философии, адъюнкт-профессор и ведущий автор исследования, сказала: “Дети из группы с допустимой степенью риска и из группы со средней степенью риска в нашем исследовании получали менее интенсивное лечение по сравнению с пациентами с высокой степенью риска. Однако среди них примерно у одного из шести возникал рецидив. Очевидно, некоторые дети нуждались в более интенсивном лечении, чем считалось ранее - но какие из них? Для группы с допустимой степенью риска и группы со средней степенью риска нам необходимо больше информации, чтобы лучше разобраться с природой онкологического заболевания у ребенка, чтобы точнее определить у него степень риска”.
Профессор Саттон добавила: “Таким образом, мы дополнили результаты MRD-анализа двумя другими блоками информации о пациентах, наличием или отсутствием микроделеций в определенных генах и показателем, который определен в качестве фактора риска Национальным институтом онкологии США и основан на возрасте и количестве лейкоцитов в крови. Мы выполнили исследование на наличие микроделеций в девяти генах, связанных с лейкозом, и обнаружили, что два из этих генов, IKZF1 (“Ikaros”) и P2RY8-CRLF2, были важными прогностическими факторами наступления рецидива”.
Эти показатели были объединены для вычисления степени риска для каждого пациента от “0“ (отсутствие факторов риска) до “2+“ (несколько). В ходе исследования было обнаружено, что у детей с показателем “2+“ вероятность рецидива или летального исхода была больше в течение семи лет после начала лечения, в то время как у детей с показателем “0“ - меньше. Было обнаружено, что точно такие же микроделеции имеют важное значение для прогнозирования рецидивов в группе голландских детей с лейкемией, и новая балльная система была проверена учеными в Нидерландах. Исследование было опубликовано 30 ноября 2017 года в журнале British Journal of Haematology.
Ссылки по теме:
Children's Cancer Institute Australia








